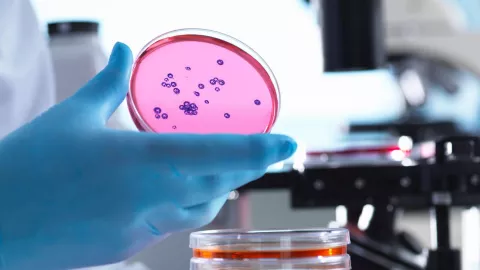
Descubren bacteria congelada

Un grupo de científicos están estudiando la cepa bacteriana Psychrobacter SC65A.3 que estuvo congelada durante 5 mil años en la cueva de Scarisoara en Rumanía y que se ha detectado que tiene una gran resistencia a antibióticos.
Suscríbete a nuestro canal de Telegram y lleva la información en tus manos.
Descubren bacteria resistente a antibióticos
La antigua bacteria fue hallada cuando los investigadores extrajeron un núcleo de hielo de 25 metros. La zona más profunda de la cueva alcanzaba 13 mil años de antigüedad y la bacteria fue aislada cerca de la mitad del testigo de hielo en la franja que ocupaba la edad cronológica de hace 5 mil años.
De acuerdo con un estudio publicado en Frontiers in Microbiology el análisis de esta bacteria esta permitiendo desarrollar nuevas estrategias para frenar el aumenta de esa resistencia y comprender cómo evoluciona y se propaga de forma natural.
La investigadora de la Academia Rumana Cristina Purcarea indicó que si el deshielo libera esos microbios podrían propagarse a las bacterias modernas y podrían inspirar nuevos antibióticos.
Resistencia a antibióticos modernos
Lo más destacado de este hallazgo es que al analizar el genoma de la bacteria descubrieron que es muy resistente a múltiples antibióticos modernos y porta más de 100 genes.
Algunos de los medicamentos a los que es resistente esta bacteria son trimetoprim, la clindamicina y el metronidazol que se utilizan para las infecciones de orina y de pulmón.
También puede inhibir el crecimiento de varias superbacterias resistentes a los antibióticos y ha demostrado importantes actividades enzimáticas con un gran potencial biotecnológico.
Con este descubrimiento, las industrias farmacéuticas, químicas o alimentarias podrían aprovechar estas bacterias para hallar nuevas vías para combatir a las superbacterias.
¿Qué es la klebsiella oxytoca y cómo se transmite?
adn Noticias. Te Hablamos con la verdad. Suscríbete a nuestro canal de WhatsApp y lleva la información en la palma de tu mano.